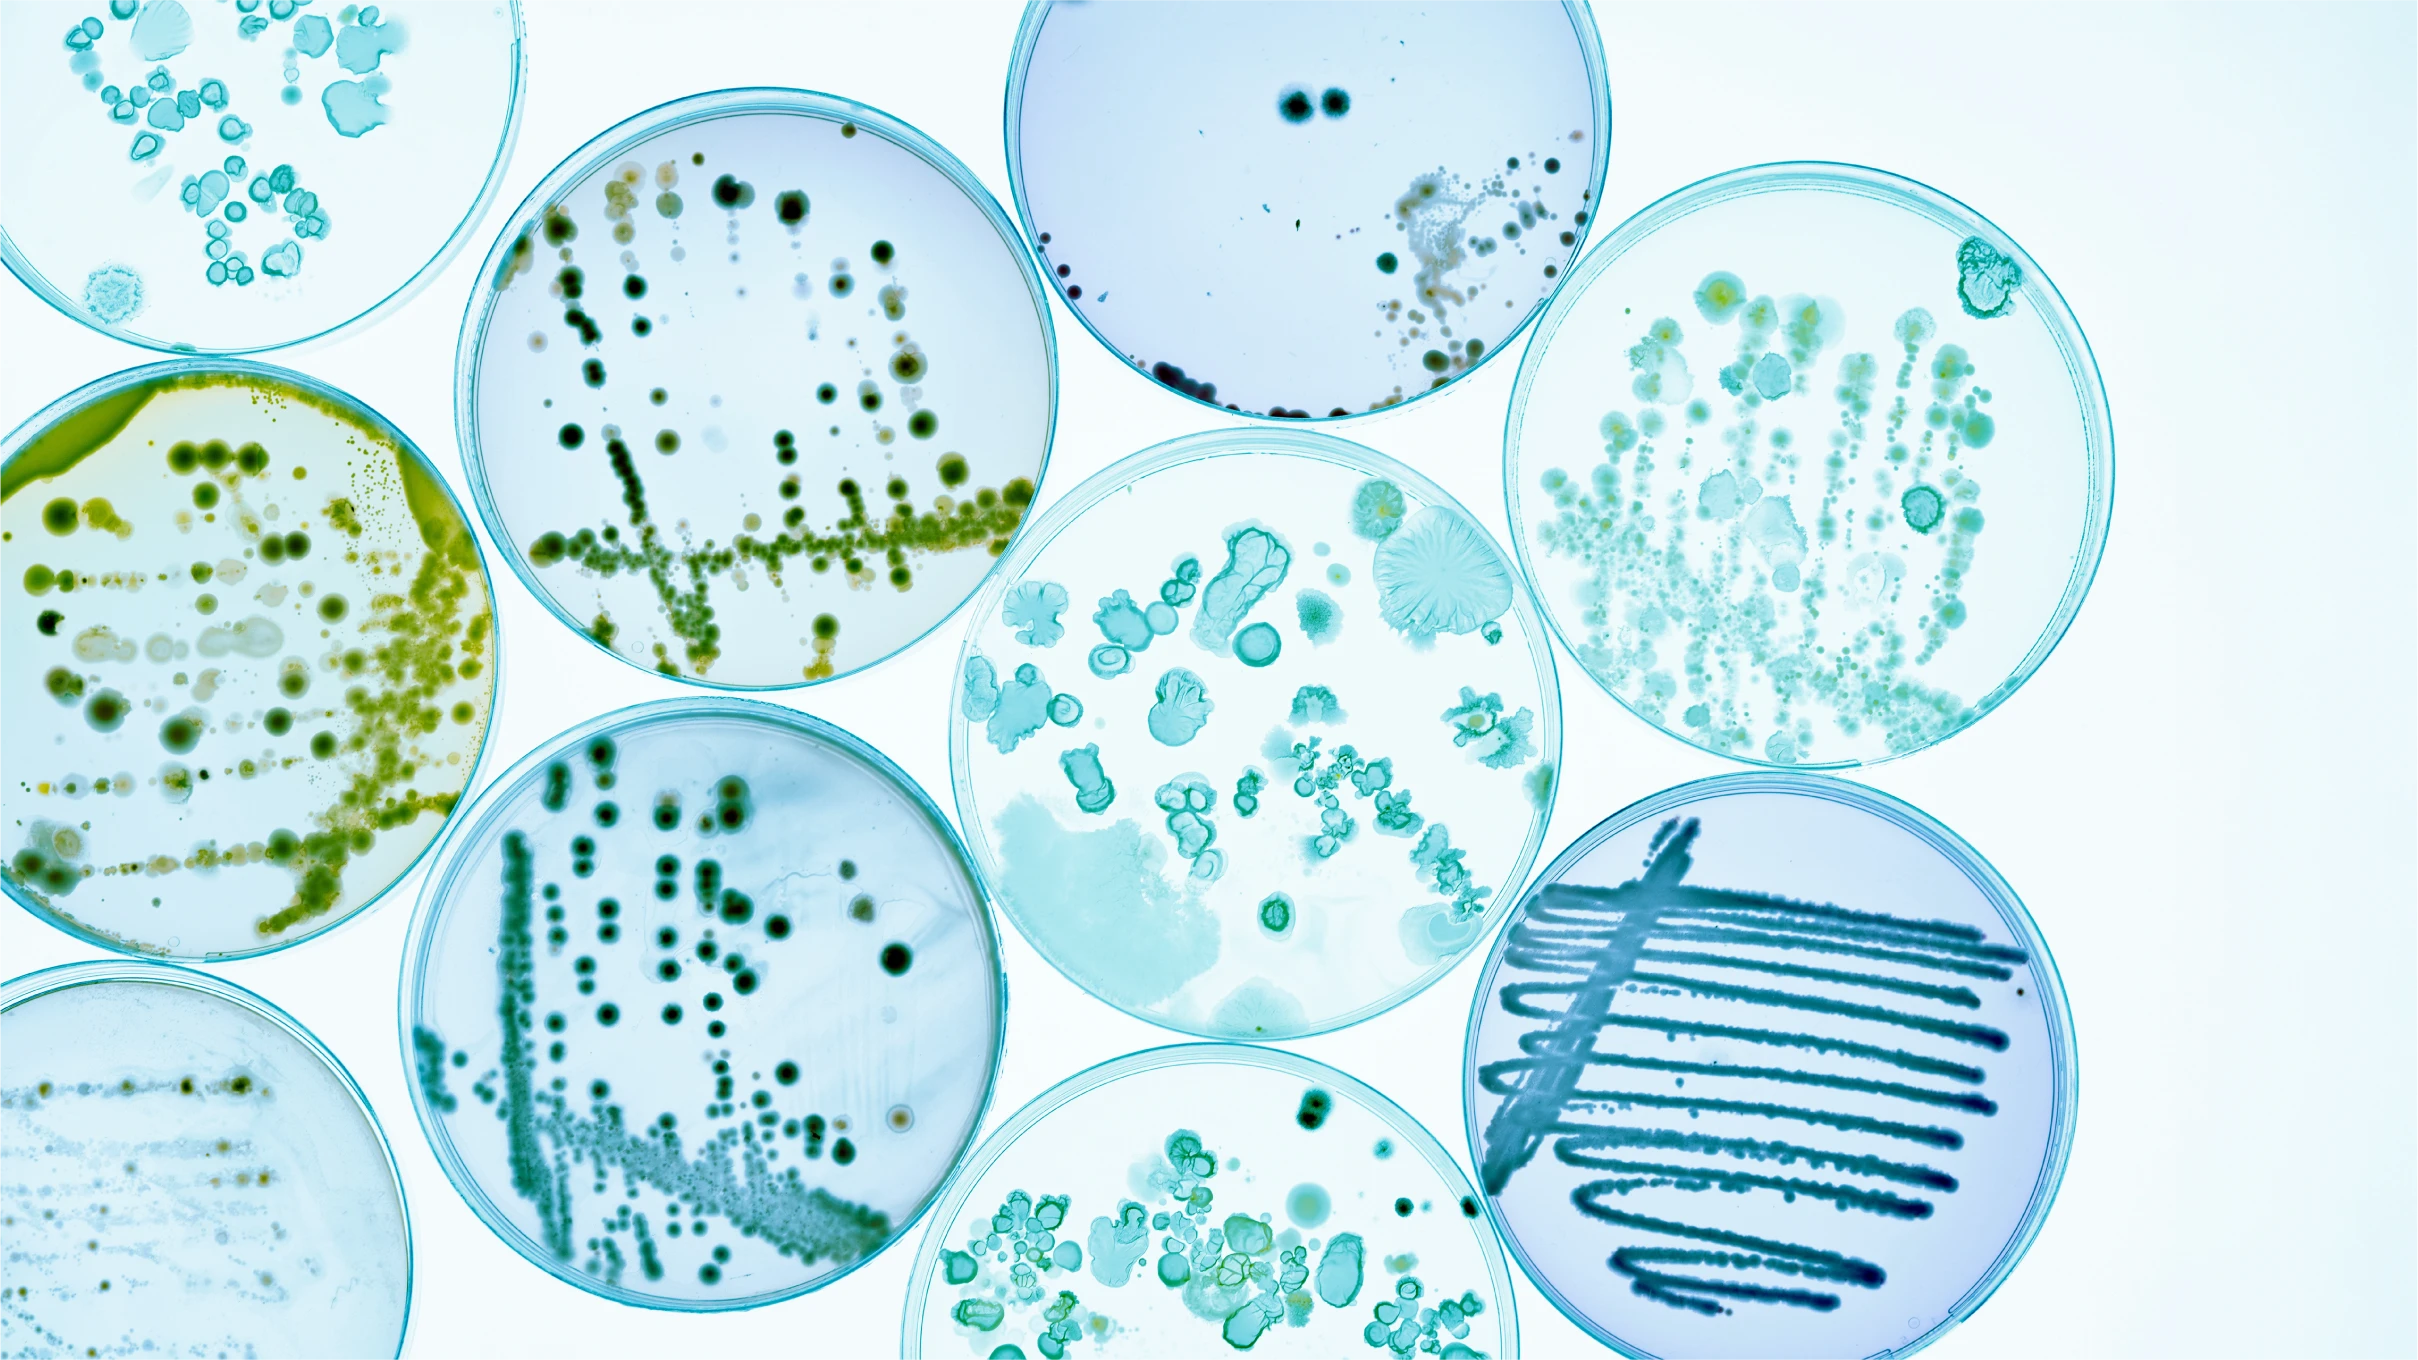
10 petri dishes with stained bacterial colonies

PTASK Preservice Teachers’ Assessment of Science Knowledge
Life Science: Preservice Teacher Assessments
Listed below are some student life science misconceptions. The list is not intended to be exhaustive, but rather a summary of some of the more common prior ideas we identified from our analysis of the student response patterns to the items on the tests.
- Organisms coexist in a habitat because they “need to get along with each other”
- Cell size is proportional to the size of the organism (elephant cells are larger than mouse cells)
- Sensory perception is an active and voluntary process
- Plants are non-living
- Plants die in the winter and are re-born in the spring
- Pollination occurs only via bees
- Any male and female animal can mate and have fertile offspring (even different species)
- Only “old” organisms die
- The larger an organism is, the older it is
- Female offspring resemble the mother; male offspring resemble the father
- Plants do not reproduce sexually
- Carnivores have no dependence on plants
- Traits acquired during an organism’s lifetime can be passed down genetically to its offspring
The following resources are useful for additional background information about students' science misconceptions:
Driver, R., et al., Making Sense of Secondary Science, Philadelphia: Open University Press (1994).
Osborne, R., & Freyberg, P., Children's science. In R. Osborne & P. Freyberg (Eds.),. Learning in Science. (pp. 5-14). Auckland, NZ: Heinemann (1985).
Bell, B., Freyberg, P., Language in the science classroom. In R. Osborne & P. Freyberg (Eds.), Learning in Science. (pp. 29-40). Auckland, NZ: Heinemann (1985).
Clough, E.E., Wood-Robinson, C., Children's understanding of inheritance. Journal of Biological Education. 19: 304-310 (1985).
Leach, J., Driver, R., Scott, P., & Wood-Robinson, C., Progression in understanding of ecological concepts by pupils aged 5 to 16. Leeds, UK: The University of Leeds, Centre for Studies in Science and Mathematics Education (1992).
Kargbo, D., Hobbs, E., & Erickson, G., Children's beliefs about inherited characteristics. Journal of Biological Education. 14: 137-146 (1980).
The test in this section contains items related to all 10 of the grades K–4 standards in life science from the NRC's National Science Education Standards (NSES); below are the standards as stated in the NSES.
K–4 Life Science Standard 1:
“Organisms have basic needs. For example, animals need air, water, and food; plants require air, water, nutrients, and light. Organisms can survive only in environments in which their needs can be met. The world has many different environments, and distinct environments support the life of different types of organisms.”
K–4 Life Science Standard 2:
“Each plant or animal has different structures that serve different functions in growth, survival, and reproduction. For example, humans have distinct body structures for walking, holding, seeing, and talking.”
K–4 Life Science Standard 3:
“The behavior of individual organisms is influenced by internal cues (such as hunger) and by external cues (such as a change in the environment). Humans and other organisms have senses that help them detect internal and external cues.”
K–4 Life Science Standard 4:
“Plants and animals have life cycles that include being born, developing into adults, reproducing, and eventually dying. The details of this life cycle are different for different organisms.”
K–4 Life Science Standard 5:
“Plants and animals closely resemble their parents.”
K–4 Life Science Standard 6:
“Many characteristics of an organism are inherited from the parents of the organism, but other characteristics result from an individual's interactions with the environment. Inherited characteristics include the color of flowers and the number of limbs of an animal. Other features, such as the ability to ride a bicycle, are learned through interactions with the environment and cannot be passed on to the next generation.”
K–4 Life Science Standard 7:
“All animals depend on plants. Some animals eat plants for food. Other animals eat animals that eat the plants.”
K–4 Life Science Standard 8:
“An organism's patterns of behavior are related to the nature of that organism's environment, including the kinds and numbers of other organisms present, the availability of food and resources, and the physical characteristics of the environment. When the environment changes, some plants and animals survive and reproduce, and others die or move to new locations.”
K–4 Life Science Standard 9:
“All organisms cause changes in the environment where they live. Some of these changes are detrimental to the organism or other organisms, whereas others are beneficial.”
K–4 Life Science Standard 10:
“Humans depend on their natural and constructed environments. Humans change environments in ways that can be either beneficial or detrimental for themselves and other organisms.”
Listed below are some student life science misconceptions. The list is not intended to be exhaustive, but rather a summary of some of the more common prior ideas we identified from our analysis of the student response patterns to the items on the tests.
- Traits developed within an organism’s lifetime can be passed down genetically to its offspring.
- Plants cannot reproduce sexually.
- All sexual reproduction involves physical mating.
- The size and shape of the cells that comprise an organism are directly correlated with the size and shape of the organism (e.g. an elephant’s cells are larger than those of a mouse; plant cells are rectangular; animal cells are round).
- Food is a requirement for growth, but not the source of matter for growth.
- When a cell is in interphase, it is “asleep.”
- Living things contain cells, but are not composed of them.
- Males of all species are larger, stronger and faster than the females. This pattern extends to genetics: A male trait is dominant and stronger than either a female trait or a recessive trait. Plants “eat” soil as their food source.
- Extinction of a species is very rare. This idea encompasses the entire history of Earth and leads to the corollary notion that most of the species alive today have always been on Earth.
- Extinction of species is mostly caused by humans.
- Respiration and breathing are the same thing.
The following resources are useful for additional background information about students' science misconceptions:
Driver, R., Pupil as Scientist?, Philadelphia: Open University Press (1983).
Driver, R., et al., Making Sense of Secondary Science, Philadelphia: Open University Press (1994).
Anderson, D. L., Fisher, K. M., & Norman, G. J. (2002). Development and evaluation of the conceptual inventory of natural selection. Journal of Research in Science Teaching, 39(10): 952–978.
Klymkowsky, M. W. & Garvin-Doxas, K .(2008). Bioliteracy-bci conceptual assessment for better learning in the biological sciences. Retrieved from http://bioliteracy.colorado.edu/
Ozkan, O., Tekkaya, C., & Geban, O. (2004). Facilitating conceptual change in students' understanding of ecological concepts. Journal of Science Education and Technology, 13(1): 95–105.
Webb, P. & Boltt, G. (1990). Food chain to food web: a natural progression? Journal of Biological Education, 24(3): 187–190.
The test in this section contains items related to 17 of the grades 5–8 standards in life science from the NRC's National Science Education Standards (NSES); below are the standards as stated in the NSES.
5–8 Life Science Standard 1:
"Living systems at all levels of organization demonstrate the complementary nature of structure and function. Important levels of organization for structure and function include cells, organs, tissues, organ systems, whole organisms, and ecosystems."
5–8 Life Science Standard 2:
"All organisms are composed of cells—the fundamental unit of life. Most organisms are single cells; other organisms, including humans, are multicellular."
5–8 Life Science Standard 3:
"Cells carry on the many functions needed to sustain life. They grow and divide, thereby producing more cells. This requires that they take in nutrients, which they use to provide energy for the work that cells do and to make the materials that a cell or an organism needs."
5–8 Life Science Standard 4:
"Specialized cells perform specialized functions in multicellular organisms. Groups of specialized cells cooperate to form a tissue, such as a muscle. Different tissues are in turn grouped together to form larger functional units, called organs. Each type of cell, tissue, and organ has a distinct structure and set of functions that serve the organism as a whole."
5–8 Life Science Standard 5:
"Disease is a breakdown in structures or functions of an organism. Some diseases are the result of intrinsic failures of the system. Others are the result of damage by infection by other organisms."
5–8 Life Science Standard 6:
"Every organism requires a set of instructions for specifying its traits. Heredity is the passage of these instructions from one generation to another."
5–8 Life Science Standard 7:
"The characteristics of an organism can be described in terms of a combination of traits. Some traits are inherited and others result from interactions with the environment."
5–8 Life Science Standard 8:
"All organisms must be able to obtain and use resources, grow, reproduce, and maintain stable internal conditions while living in a constantly changing external environment."
5–8 Life Science Standard 9:
"Regulation of an organism's internal environment involves sensing the internal environment and changing physiological activities to keep conditions within the range required to survive."
5–8 Life Science Standard 10:
"Behavior is one kind of response an organism can make to an internal or environmental stimulus. A behavioral response requires coordination and communication at many levels, including cells, organ systems, and whole organisms. Behavioral response is a set of actions determined in part by heredity and in part from experience."
5–8 Life Science Standard 11:
"An organism's behavior evolves through adaptation to its environment. How a species moves, obtains food, reproduces, and responds to danger are based in the species' evolutionary history."
5–8 Life Science Standard 12:
"A population consists of all individuals of a species that occur together at a given place and time. All populations living together and the physical factors with which they interact compose an ecosystem."
5–8 Life Science Standard 13:
"Populations of organisms can be categorized by the function they serve in an ecosystem. Plants and some micro-organisms are producers—they make their own food. All animals, including humans, are consumers, which obtain food by eating other organisms. Decomposers, primarily bacteria and fungi, are consumers that use waste materials and dead organisms for food. Food webs identify the relationships among producers, consumers, and decomposers in an ecosystem."
5–8 Life Science Standard 14:
"For ecosystems, the major source of energy is sunlight. Energy entering ecosystems as sunlight is transferred by producers into chemical energy through photosynthesis. That energy then passes from organism to organism in food webs."
5–8 Life Science Standard 15:
"The number of organisms an ecosystem can support depends on the resources available and abiotic factors, such as quantity of light and water, range of temperatures, and soil composition. Given adequate biotic and abiotic resources and no disease or predators, populations (including humans) increase at rapid rates. Lack of resources and other factors, such as predation and climate, limit the growth of populations in specific niches in the ecosystem."
5–8 Life Science Standard 16:
"Biological evolution accounts for the diversity of species developed through gradual processes over many generations. Species acquire many of their unique characteristics through biological adaptation, which involves the selection of naturally occurring variations in populations. Biological adaptations include changes in structures, behaviors, or physiology that enhance survival and reproductive success in a particular environment."
5–8 Life Science Standard 17:
"Extinction of a species occurs when the environment changes and the adaptive characteristics of a species are insufficient to allow its survival. Fossils indicate that many organisms that lived long ago are extinct. Extinction of species is common; most of the species that have lived on the earth no longer exist."
Listed below are some student life science misconceptions, grouped under the four main standards of the NGSS for grades 9–12 life science. The list is not intended to be exhaustive, but rather a summary of some of the more common prior ideas we identified from our analysis of the student response patterns to the items on all of our field tests, which totaled more than 500 items.
Standard HS-LS1: From Molecules to Organisms: Structures and Functions
- Students are unsure about the hierarchy of atoms, molecules, and cells.
- Students broadly have difficulty with the concepts of conservation of mass and of energy.
- Some living parts of organisms are not made of cells.
- The increase in the size of an organism is mostly (or entirely) due to an increase in the size of its cells.
- Students confuse breathing and respiration.
- When an organism is in homeostasis, no change takes place and the internal conditions are stable.
- Students who feel overburdened by terminology in cell division discover finding differences and similarities between the mitosis and meiosis processes to be difficult, which then affects their whole understanding of cell division.
- Students generally think that plants absorb food from the soil rather than manufacturing it.
- Organic compounds are only things that organisms consume, they are not made by organisms and/or organisms are not composed of organic compounds.
- Students assume that an organism that is not a plant must be an animal, and vice versa.
Standard HS-LS2: Ecosystems: Interactions, Energy, and Dynamics
- Population is the number of people/organisms in a certain area at one time.
- Communities are the same as populations.
- Humans are not part of an ecosystem. (Even more broadly, some students consider humans to be unique, having nothing in common with any other organism.)
- Organisms higher in a food web eat everything that is lower in the food web.
- Organisms higher in a food web obtain nothing from organisms lower in the food web.
- Students have difficulty applying the carbon cycle to real-world scenarios.
- Species coexist in an ecological system because of their compatible needs and behaviors: they need to get along.
- There is no relationship between plants and animals in terms of energy because both plants and animals have their own energy.
- Carnivores have more energy than herbivores.
- Natural events such as volcanic eruptions, floods, landslides, forest fires, and earthquakes cause more habitat destruction than humans.
- Only humans can destroy habitats.
Standard HS-LS3: Heredity: Inheritance and Variation of Traits
- The uses of the words “genes,” “DNA,” and “chromosomes” are interchanged in trying to explain how traits are passed from one generation to the next.
- Students become distracted by the mechanics of genetics problems and fail to understand the underlying significance of the processes.
- Genes are only found in specific organs or tissues (e.g. reproductive system).
- Students assume that mutations in DNA are always harmful.
- There is confusion between inherited changes in populations of organisms over time and non-inherited changes occurring within the lifetime of an organism.
- Students may think that all traits are adaptive, or that all traits are genetic.
Standard HS-LS4: Biological Evolution: Unity and Diversity
- No one was there to observe evolution, so no one knows what happened.
- Evolution depends upon random events, so organization cannot arise.
- Evolution is like a climb up a ladder of progress: organisms are always getting better.
- Natural selection involves organisms ‘trying’ to adapt.
- Natural selection gives organisms what they ‘need.’*
- The phrase “survival of the fittest” is invoked by students when thinking about natural selection and evolution. The phrase tends to cause students to consider factors such as size and strength as key variables, and to fail to identify genetic variation and reproductive success as essential factors.
- Humans do not share a common ancestor with any other type of organism.
- Evolution is a process in the distant past, e.g., it might explain dinosaurs and trilobites, but it does not continue to occur in living populations.
- Until recently, extinction was rare; humans have caused the majority of extinctions.
- Only certain types of organisms can go extinct.
- Students confuse “biodiversity” and “environment.”
- Students often only define biodiversity as diversity of animals.
- Students cannot distinguish the difference between species diversity and genetic diversity.
- Biodiversity of other species is not relevant to humans.
Selected References for Grades 9–12 Life Science Misconceptions
Anderson, D.L., Fisher, K.M., & Norman, G.J. (2002). “Development and evaluation of the conceptual inventory of natural selection.” Journal of Research in Science Teaching, 39(10): 952–978.
Barak, J., Sheva, B., & Gorodetsky, M. (1999). “As ‘process’ as it can get: students’ understanding of biological processes.” International Journal of Science Education, 21 (12): 1281–1292.
Barman, C., Stein, M., Barman, N., & McNair, S. (2003). “Students’ ideas about plants: results from a national study.” Science and Children, 41(1): 46–51.
Driver, R., Squires, A., Rushworth, P., & Wood-Robinson, V. (1994). Making Sense of Secondary Science: Research into Children’s Ideas. New York, NY: Routledge.
Flores F., Tovar, M. E., & Gallegos, L. (2003). “Representation of the cell and its processes in high school students: An integrated view.” International Journal of Science Education. 25(2): 269–286.
Gallegos, L., Jerezano, M., & Flores, F. (1994). “Preconceptions and relations used by children in the construction of food chains.” Journal of Research in Science Teaching, 31(3): 259–272.
Gregory, T. R. (2009). “Understanding Natural Selection: Essential concepts and common misconceptions.” Evolution: Education and Outreach, 2: 156–175.
Leach, J., Driver, R., Scott, P., & Wood-Robinson, C. (1992). Progression in understanding of ecology concepts by pupils aged 5 to 16. CLIS (Children’s Learning in Science Research Group, Centre for Studies in Science and Mathematics Education), Leeds: University of Leeds.
Leach, J., Driver, R., Scott, P., & Wood-Robinson, C. (1996). “Children’s ideas about ecology 2: ideas found in children aged 5–16 about the cycling of matter.” International Journal of Science Education, 18(1): 19–34.
Leach, J., Driver, R., Scott, P., & Wood-Robinson, C. (1996). “Children’s ideas about ecology 3: ideas found in children aged 5–16 about the interdependency of organisms.” International Journal of Science Education, 18(2): 129–141.
Lewis, J., & Kattmann, U. (2004). “Traits, genes, particles and information: Re- visiting students’ understandings of genetics.” International Journal of Science Education, 26(2): 195–206.
Lewis, J., & Wood-Robinson, C. (2000). “Genes, chromosomes, cell division and inheritance: Do students see any relationship?” International Journal of Science Education, 22(2): 177–195.
Lewis, J., Leach, J., & Wood-Robinson, C. (2000). “What’s in a cell? Young people’s understanding of the genetic relationship between cells, within an individual.” Journal of Biological Education, 34(3): 129–132.
Webb, P., & Boltt, G. (1990). “Food chain to food web: a natural progression?” Journal of Biological Education, 24(3): 187–190.
The test in this section contains items related to 29 of the grades 9–12 Disciplinary Core Ideas (DCIs) in life science from the Next Generation Science Standards (NGSS). Listed below are the DCIs as stated in the NGSS. DCIs are designated as in the NGSS.
HS-LS1.A.i:
“Systems of specialized cells within organisms help them perform the essential functions of life.”
HS-LS1.A.ii:
“All cells contain genetic information in the form of DNA molecules. Genes are regions in the DNA that contain the instructions that code for the formation of proteins, which carry out most of the work of cells.”
HS-LS1.A.iii:
“Multicellular organisms have a hierarchical structural organization, in which any one system is made up of numerous parts and is itself a component of the next level.”
HS-LS1.A.iv:
“Feedback mechanisms maintain a living system’s internal conditions within certain limits and mediate behaviors, allowing it to remain alive and functional even as external conditions change within some range. Feedback mechanisms can encourage (through positive feedback) or discourage (negative feedback) what is going on inside the living system.”
HS-LS1.B.i:
“In multicellular organisms individual cells grow and then divide via a process called mitosis, thereby allowing the organism to grow. The organism begins as a single cell (fertilized egg) that divides successively to produce many cells, with each parent cell passing identical genetic material (two variants of each chromosome pair) to both daughter cells. Cellular division and differentiation produce and maintain a complex organism, composed of systems of tissues and organs that work together to meet the needs of the whole organism.”
HS-LS1.C.i:
“The process of photosynthesis converts light energy to stored chemical energy by converting carbon dioxide plus water into sugars plus released oxygen.”
HS-LS1.C.ii:
“The sugar molecules thus formed contain carbon, hydrogen, and oxygen: their hydrocarbon backbones are used to make amino acids and other carbon-based molecules that can be assembled into larger molecules (such as proteins or DNA), used for example to form new cells.”
HS-LS1.C.iii:
“As matter and energy flow through different organizational levels of living systems, chemical elements are recombined in different ways to form different products.”
HS-LS1.C.iv:
“As a result of these chemical reactions, energy is transferred from one system of interacting molecules to another. Cellular respiration is a chemical process in which the bonds of food molecules and oxygen molecules are broken and new compounds are formed that can transport energy to muscles. Cellular respiration also releases the energy needed to maintain body temperature despite ongoing energy transfer to the surrounding environment.”
HS-LS2.A.i:
“Ecosystems have carrying capacities, which are limits to the numbers of organisms and populations they can support. These limits result from such factors as the availability of living and nonliving resources and from such challenges such as predation, competition, and disease. Organisms would have the capacity to produce populations of great size were it not for the fact that environments and resources are finite. This fundamental tension affects the abundance (number of individuals) of species in any given ecosystem.”
HS-LS2.B.i:
“Photosynthesis and cellular respiration (including anaerobic processes) provide most of the energy for life processes.”
HS-LS2.B.ii:
(separated into sentences for easier reading)- Plants or algae form the lowest level of the food web.
- At each link upward in a food web, only a small fraction of the matter consumed at the lower level is transferred upward, to produce growth and release energy in cellular respiration at the higher level.
- Given this inefficiency, there are generally fewer organisms at higher levels of a food web.
- Some matter reacts to release energy for life functions, some matter is stored in newly made structures, and much is discarded.
- The chemical elements that make up the molecules of organisms pass through food webs and into and out of the atmosphere and soil, and they are combined and recombined in different ways.
- At each link in an ecosystem, matter and energy are conserved.
HS-LS2.B.iii:
“Photosynthesis and cellular respiration are important components of the carbon cycle, in which carbon is exchanged among the biosphere, atmosphere, oceans, and geosphere through chemical, physical, geological, and biological processes.”
HS-LS2.C.i:
“A complex set of interactions within an ecosystem can keep its numbers and types of organisms relatively constant over long periods of time under stable conditions. If a modest biological or physical disturbance to an ecosystem occurs, it may return to its more or less original status (i.e., the ecosystem is resilient), as opposed to becoming a very different ecosystem. Extreme fluctuations in conditions or the size of any population, however, can challenge the functioning of ecosystems in terms of resources and habitat availability.”
HS-LS2.C.ii:
“Moreover, anthropogenic changes (induced by human activity) in the environment—including habitat destruction, pollution, introduction of invasive species, overexploitation, and climate change—can disrupt an ecosystem and threaten the survival of some species.”
HS-LS2.D.i:
“Group behavior has evolved because membership can increase the chances of survival for individuals and their genetic relatives.”
HS-LS3.A.i:
“Each chromosome consists of a single very long DNA molecule, and each gene on the chromosome is a particular segment of that DNA. The instructions for forming species’ characteristics are carried in DNA. All cells in an organism have the same genetic content, but the genes used (expressed) by the cell may be regulated in different ways. Not all DNA codes for a protein; some segments of DNA are involved in regulatory or structural functions, and some have no as-yet known function.”
HS-LS3.B.i:
“In sexual reproduction, chromosomes can sometimes swap sections during the process of meiosis (cell division), thereby creating new genetic combinations and thus more genetic variation. Although DNA replication is tightly regulated and remarkably accurate, errors do occur and result in mutations, which are also a source of genetic variation. Environmental factors can also cause mutations in genes, and viable mutations are inherited.”
HS-LS3.B.ii:
“Environmental factors also affect expression of traits, and hence affect the probability of occurrences of traits in a population. Thus the variation and distribution of traits observed depends on both genetic and environmental factors.”
HS-LS4.A.i:
“Genetic information provides evidence of evolution. DNA sequences vary among species, but there are many overlaps; in fact, the ongoing branching that produces multiple lines of descent can be inferred by comparing the DNA sequences of different organisms. Such information is also derivable from the similarities and differences in amino acid sequences and from anatomical and embryological evidence.”
HS-LS4.B.i:
“Natural selection occurs only if there is both (1) variation in the genetic information between organisms in a population and (2) variation in the expression of that genetic information—that is, trait variation—that leads to differences in performance among individuals.”
HS-LS4.B.ii:
“The traits that positively affect survival are more likely to be reproduced, and thus are more common in the population.”
HS-LS4.C.i:
“Evolution is a consequence of the interaction of four factors: (1) the potential for a species to increase in number, (2) the genetic variation of individuals in a species due to mutation and sexual reproduction, (3) competition for an environment’s limited supply of the resources that individuals need in order to survive and reproduce, and (4) the ensuing proliferation of those organisms that are better able to survive and reproduce in that environment.”
HS-LS4.C.ii:
“Natural selection leads to adaptation, that is, to a population dominated by organisms that are anatomically, behaviorally, and physiologically well suited to survive and reproduce in a specific environment. That is, the differential survival and reproduction of organisms in a population that have an advantageous heritable trait leads to an increase in the proportion of individuals in future generations that have the trait and to a decrease in the proportion of individuals that do not.”
HS-LS4.C.iii:
“Adaptation also means that the distribution of traits in a population can change when conditions change.”
HS-LS4.C.iv:
“Changes in the physical environment, whether naturally occurring or human induced, have thus contributed to the expansion of some species, the emergence of new distinct species as populations diverge under different conditions, and the decline–and sometimes the extinction–of some species.”
HS-LS4.C.v:
“Species become extinct because they can no longer survive and reproduce in their altered environment. If members cannot adjust to change that is too fast or drastic, the opportunity for the species’ evolution is lost.”
HS-LS4.D.i:
“Biodiversity is increased by the formation of new species (speciation) and decreased by the loss of species (extinction).”
HS-LS4.D.ii:
“Humans depend on the living world for the resources and other benefits provided by biodiversity. But human activity is also having adverse impacts on biodiversity through overpopulation, overexploitation, habitat destruction, pollution, introduction of invasive species, and climate change. Thus sustaining biodiversity so that ecosystem functioning and productivity are maintained is essential to supporting and enhancing life on Earth. Sustaining biodiversity also aids humanity by preserving landscapes of recreational or inspirational value.”
